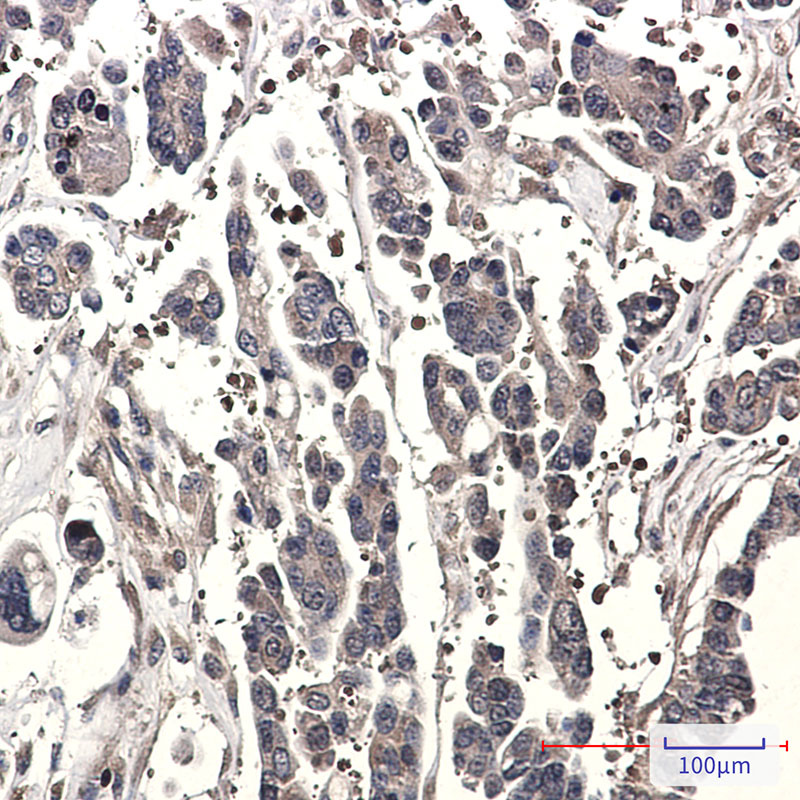

-
分类: 科研抗体货号: P22562别名: 60S acidic ribosomal protein P1; AA409079; AI325195; AU020965; HSSB; ik:tdsubc_2g1; M(2)21C; MGC137236; OTTHUMP00000004008; p32; p34; RCJMB04_6d17 replication protein A2; 32kDa; REPA 2; REPA1; REPA2; Replication factor A protein 2; Replication protein A 3应用: WB,IP,IHC反应种属: Human
-
分类: 科研抗体货号: P22545别名: DLAT; DLTA; E2; PBC; PDCE2应用: WB,IP,IF反应种属: Human,Mouse,Rat,Hamster
-
分类: 科研抗体货号: P22561别名: RNF14; ARA54; HRIHFB2038; E3 ubiquitin-protein ligase RNF14; Androgen receptor-associated protein 54; HFB30; RING finger protein 14; Triad2 protein应用: WB反应种属: Human,Mouse,Rat
-
分类: 科研抗体货号: P22572别名: JMH; CD108; SEMAL; CDw108; SEMAK1; H-Sema-L; H-SEMA-K1应用: WB,IP,IHC反应种属: Human
-
分类: 科研抗体货号: P22560别名: ARHGDIA; GDIA1; Rho GDP-dissociation inhibitor 1; Rho GDI 1; Rho-GDI alpha应用: WB,IF反应种属: Human,Mouse,Rat
-
分类: 科研抗体货号: P22571别名: CLCRP2应用: WB反应种属: Human,Mouse,Rat
-
分类: 科研抗体货号: P22559别名: regulator of G protein signaling 6; GAP; S914; HA117应用: WB反应种属: Human
-
分类: 科研抗体货号: P22570别名: SDS; SWDS; CGI-97应用: WB,IP,IF反应种属: Human
-
分类: 科研抗体货号: P22584别名: STK39; SPAK; STE20/SPS1-related proline-alanine-rich protein kinase; Ste-20-related kinase; DCHT; Serine/threonine-protein kinase 39应用: WB,IHC反应种属: Human
-
分类: 科研抗体货号: P22569别名: NSP; SARA; MADHIP; SMADIP; PPP1R173应用: WB,IP,IHC反应种属: Human

鄂公网安备42018502007531号
鄂公网安备42018502007531号

